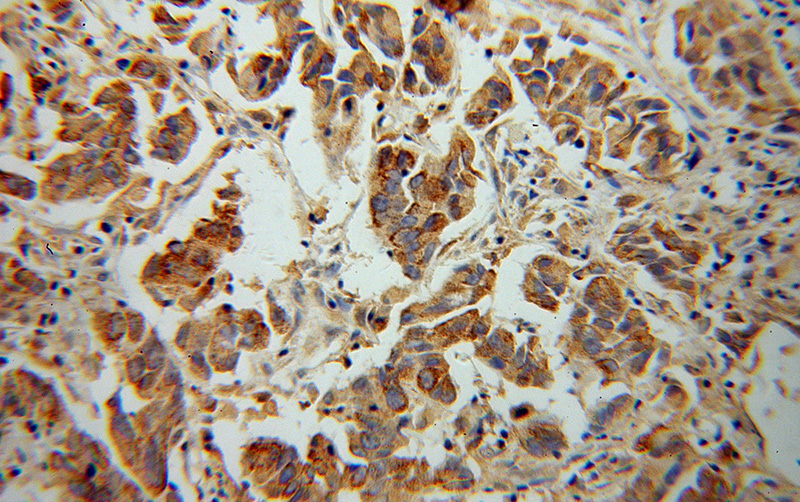
Immunohistochemical of paraffin-embedded human prostate cancer using Catalog No:109681(CYP17A1 antibody) at dilution of 1:100 (under 40x lens)

-
Product Name
CYP17A1 antibody
- Documents
-
Description
CYP17A1 Rabbit Polyclonal antibody. Positive WB detected in HeLa cells, A549 cells, HepG2 cells, Jurkat cells, mouse brain tissue, rat brain tissue. Positive IF detected in HepG2 cells. Positive IHC detected in human prostate cancer tissue. Observed molecular weight by Western-blot: 48-51 kDa
-
Tested applications
ELISA, IHC, IF, WB
-
Species reactivity
Human; other species not tested.
-
Alternative names
CPT7 antibody; CYP17 antibody; CYP17A1 antibody; CYPXVII antibody; CytOChrome P450 17A1 antibody; CytOChrome P450 C17 antibody; CytOChrome P450c17 antibody; P450C17 antibody; S17AH antibody; Steroid 17 alpha monooxygenase antibody
-
Isotype
Rabbit IgG
-
Preparation
This antibody was obtained by immunization of CYP17A1 recombinant protein (Accession Number: NM_000102). Purification method: Antigen affinity purified.
-
Clonality
Polyclonal
-
Formulation
PBS with 0.02% sodium azide and 50% glycerol pH 7.3.
-
Storage instructions
Store at -20℃. DO NOT ALIQUOT
-
Applications
Recommended Dilution:
WB: 1:200-1:2000
IHC: 1:20-1:200
IF: 1:20-1:200
-
Validations

Immunohistochemical of paraffin-embedded human prostate cancer using Catalog No:109681(CYP17A1 antibody) at dilution of 1:100 (under 10x lens)
Immunohistochemical of paraffin-embedded human prostate cancer using Catalog No:109681(CYP17A1 antibody) at dilution of 1:100 (under 40x lens)

Immunofluorescent analysis of HepG2 cells, using CYP17A1 antibody Catalog No:109681 at 1:50 dilution and Rhodamine-labeled goat anti-rabbit IgG (red). Blue pseudocolor = DAPI (fluorescent DNA dye).

HeLa cells were subjected to SDS PAGE followed by western blot with Catalog No:109681(CYP17A1 Antibody) at dilution of 1:600
-
Background
The human cytochrome P450c17 enzyme is encoded by the CYP17A1 gene. It is the qualitative regulator of steroidogenesis in the human adrenals.In its absence, aldosterone is produced in the human adrenal zona glomerulosa .The CYP17A1 gene is expressed in the adrenal cortex and the gonads but not in the placenta (PMID;19403566). Although CYP17A1 has been shown to be a 50-kDa protein, the presence of a lower molecular mass(30 kDa) immunoreactive form in rat Ley- dig cells was previously shown and it is either a degradation product or a truncated form of the 50 kDa enzyme(PMID:15761033). Defects in CYP17A1 are the cause of adrenal hyperplasia type 5 (AH5).
-
References
- Chrusciel M, Vuorenoja S, Mohanty B. Transgenic GATA-4 expression induces adrenocortical tumorigenesis in C57Bl/6 mice. Journal of cell science. 126(Pt 8):1845-57. 2013.
- Tong A, Jia A, Yan S, Zhang Y, Xie Y, Liu G. Ectopic cortisol-producing adrenocortical adenoma in the renal hilum: histopathological features and steroidogenic enzyme profile. International journal of clinical and experimental pathology. 7(7):4415-21. 2014.
- Huhtinen K, Saloniemi-Heinonen T, Keski-Rahkonen P. Intra-tissue steroid profiling indicates differential progesterone and testosterone metabolism in the endometrium and endometriosis lesions. The Journal of clinical endocrinology and metabolism. 99(11):E2188-97. 2014.
- Bremmer F, Jarry H, Strauß A, Behnes CL, Trojan L, Thelen P. Increased expression of CYP17A1 indicates an effective targeting of the androgen receptor axis in castration resistant prostate cancer (CRPC). SpringerPlus. 3:574. 2014.
- Robitaille CN, Rivest P, Sanderson JT. Antiandrogenic mechanisms of pesticides in human LNCaP prostate and H295R adrenocortical carcinoma cells. Toxicological sciences : an official journal of the Society of Toxicology. 143(1):126-35. 2015.
- Hakkarainen J, Jokela H, Pakarinen P. Hydroxysteroid (17β)-dehydrogenase 1-deficient female mice present with normal puberty onset but are severely subfertile due to a defect in luteinization and progesterone production. FASEB journal : official publication of the Federation of American Societies for Experimental Biology. 29(9):3806-16. 2015.
Related Products / Services
Please note: All products are "FOR RESEARCH USE ONLY AND ARE NOT INTENDED FOR DIAGNOSTIC OR THERAPEUTIC USE"
